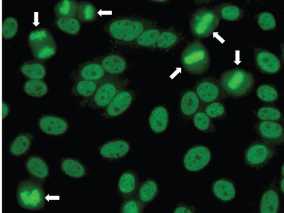
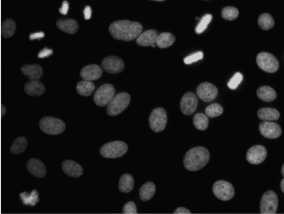

Линейные иммунные анализы
- Решения для широкого спектра показаний
- До 18 аутоантител в одном анализе
- Высокое качество продукции для получения надёжных результатов
Специфическая диагностика и дифференциация
Высокое качество продукции для получения надёжных результатов
Линейные иммуноанализы готовятся путём нанесения антигенов в виде линий на нитроцеллюлозную мембрану. Связанные аутоантитела выявляются с помощью вторичных антител, конъюгированных с пероксидазой хрена, и субстрата, специфичного для ЛИА.
Наличие линии контроля порогового значения упрощает определение положительных образцов. Это также даёт возможность обнаружения пограничных и отрицательных результатов, что позволяет очень раннее выявление наличия аутоантител. IMTEC-LIA находится под пристальным контролем на протяжении всего процесса производства.
Согласованность результатов регулярно проверяется в ходе внешних испытаний по контролю качества.


Новая инновационная продукция
Уникальный тест IMTEC-Arthritis-LIA включает все параметры, необходимые для диагностики ревматоидного артрита. Он содержит параметр АЦЦП (антитела к циклическому цитруллинированному пептиду) и ревматоидный фактор, рекомендованные критериями ACR/EULAR для диагностики ревматоидного артрита. Тест дополнен полоской для определения антител к RA33 для улучшения прогнозирования заболевания и полосками для определения антител к SSA и SSB для раннего обнаружения пересечения с синдромом Шегрена. Наряду с новым тестом IMTEC-ANA-LIA XL, специально разработанным для повышения точности диагностики ревматических заболеваний, и обновлённым ПО HumaScanFA компания HUMAN продолжает заниматься внедрением инновационных средств диагностики аутоиммунных заболеваний.

3O-летний опыт в диагностике аутоиммунных заболеваний
Компания IMTEC GmbH была основана в 1990 году и с 2006 года входит в состав группы компаний HUMAN.
На протяжении 30 лет IMTEC является торговой маркой перспективных продуктов в области аутоиммунной диагностики.


Упрощение обработки и интерпретации ЛИА с помощью HumaBlot 44FA и HumaScanFA
HumaBlot 44FA – полностью автоматизированная система обработки линейных иммуноанализов. Она выполняет все этапы: от обработки и разведения образцов и реагентов до сканирования тест-полосок и интерпретации результатов теста. Интерпретацию ЛИА можно выполнять с помощью ПО HumaScanFA, которое интегрировано в анализатор HumaBlot 44FA, но может также использоваться отдельно с планшетным сканером.

Подробную информацию см. по ссылке: www.human.de/autoimmune-instruments
Расширенная панель – улучшенная эффективность
- Определение 18 аутоантител
- Дополнительный маркер DFS70 для исключения системных ревматических заболеваний
- Готовый к применению буфер для разведения


Расширенная панель – улучшенная эффективность
ANA-LIA-XL – Улучшен для оптимизации диагностики
Благодаря многопараметрическому анализу, а также простоте и надёжности обработки значение линейных иммуноферментных анализов (ЛИА) в диагностике аутоиммунных заболеваний повысилось.
Тест IMTEC-ANA-LIA XL – это новое поколение хорошо себя зарекомендовавшего теста ANA-LIA Maxx. Он является результатом непрерывного развития на основании отзывов клиентов и требований лабораторий и демонстрирует нашу приверженность высококачественным решениям.
Новый ЛИА содержит антиген DFS70 в качестве дополнительного маркера и оптимизированный готовый к использованию буфер для разведения. Новый жидкий буфер для разведения можно наносить напрямую, поэтому его использование проще и безопаснее.

DFS70 – Полезный маркер для исключения системных ревматических заболеваний
Исследование профилей антител играет важную роль в диагностике аутоиммунных заболеваний. Тест ANA LIA Maxx уже предоставляет обзор соответствующих маркеров АНА для подтверждения диагностики ревматических заболеваний и перекрёстных синдромов. Эти преимущества сохраняются и в новом тесте ANA-LIA XL. В ЛИА добавлена дополнительная функция благодаря наличию DFS70 в качестве маркера исключения системных ревматических заболеваний.
Реакция иммунофлюоресценции (РИФ) показывает схожий рисунок для DFS70 и dsDNA
Во время реакции иммунофлюоресценции на клетках HEp-2 аутоантитела к DFS70 демонстрируют ядерный плотный мелкогранулярный рисунок АНА, который очень похож на классический гомогенный рисунок АНА, характерный для аутоантител к dsDNA. Тест ANA-LIA XL сразу выполняет дифференцировку dsDNA и DFS70.
Рисунок Anti-DFS70 РИФ
Окрашивание ДНК
Рисунок плотных мелких гранул (DFS), визуализированный с помощью реакции иммунофлюоресценции (РИФ) на предметных стёклах клеток HEp-2 с использованием сыворотки с моноспецифическими человеческими анти-DFS70. Стрелки указывают на характерное яркое окрашивание митотических хромосом.
Антитела к DFS70 имеют значимость только в том случае, если они встречаются изолированно
Изолированные антитела к DFS70, которые появляются на ЛИА, помогают выявить ложноположительные результаты РИФ. Это обеспечивает большую надёжность при исключении ревматических заболеваний. Благодаря большому количеству различных антигенов в одном тесте, ЛИА является идеальным методом, чтобы определить, присутствуют ли антитела к DFS 70 изолированно или в сочетании с другими антителами.

671 пациент ревматологической поликлиники был обследован на наличие антител к DFS70. У всех пациентов, у которых было исключено ревматическое заболевание и одновременно выявлены антитела к DFS70, антитела к DFS70 были обнаружены изолированно. Ни один из других маркеров АНА не был положительным
Тест ANA-LIA XL показывает превосходные результаты в сравнении с референсным тестом
В сравнении с референсом, ЛИА IMTEC показывает согласованность 98% со 100% чувствительностью и специфичность 97%.

Расширенная панель – улучшенная эффективность
В разработке
HumaBlot 44FA и HumaScanFA упрощают обработку и интерпретацию ЛИА
Анализатор HumaBlot 44FA является полностью автоматизированной системой для обработки линейных иммуноанализов. Он выполняет все этапы - от обработки и разведения образцов и реагентов до сканирования тест-полосок и интерпретации результатов теста. Благодаря возможности работы без нахождения персонала рядом с анализатором, гибкой настройке количества тестов и возможности выполнения до 44 тестов в серии, он идеально подходит для лабораторий с низкой и высокой пропускной способностью, а также для лабораторий с высокими требованиями к обеспечению качества. Интерпретацию ЛИА можно выполнять с помощью ПО HumaScanFA, которое интегрированно в HumaBlot 44FA, однако может использоваться и отдельно вместе с планшетным сканером.
Подробную итнформацию см. по ссылке: www.human.de/autoimmune-instruments
1. Ortiz-Hernandez, G.L., Sanchez-Hernandez, E.S. & Casiano, C.A. Twenty years of research on the DFS70/LEDGF autoantibody-autoantigen system: many lessons learned but still many questions. Autoimmun Highlights 11, 3 (2020). https://doi.org/10.1186/s13317-020-0126-4
2. Data from Salzer U et al. THU0380. DOI: 10.1136/annrheumdis-2018-eular.6479 (10).
3. Clin Rev Allergy Immunol. 2016 Jun 28. [Epub ahead of print] Review. PubMed PMID: 27350273.
4. Infantino M, Bizzaro N, Grossi V, Manfredi M. The long-awaited, pseudo-DFS pattern. Expert Rev Clin Immunol. 2019 15(5):445.
5. Dellavance A, Baldo DC, Zheng B, Mora RA, Fritzler MJ, Hiepe F, Ronnelid J, Satoh M, Garcia-De La Torre I, Wener MH, Chan EKL, Andrade LEC. Establishment of an international autoantibody reference standard for human anti-DFS70 antibodies: proof-of-concept study for a novel Megapool strategy by pooling individual specific sera. Clin Chem Lab Med. 2019;57:1754-63
6. Ortiz-Hernandez, G.L., Sanchez-Hernandez, E.S. & Casiano, C.A. Twenty years of research on the DFS70/LEDGF autoantibody-autoantigen system: many lessons learned but still many questions. Autoimmun Highlights 11, 3 (2020). https://doi.org/10.1186/s13317-020-0126-4


